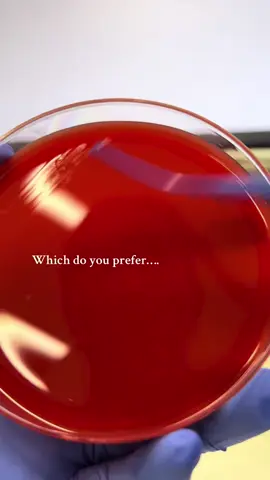

Thế Lâm
Region: VN
Thursday 25 September 2025 01:34:30 GMT
1915
32
1
32
Music
Download
Comments
ℂ𝕦̛𝕠̛̀𝕟𝕘 ℍ𝕒𝕚𝕣 :
Ok đấy
2025-09-25 10:45:42
0
To see more videos from user @thelam3502, please go to the Tikwm
homepage.